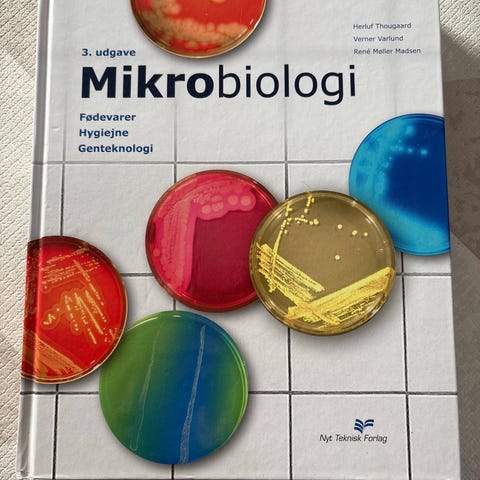

Fiks færdig
250 kr.
Stand: Brugt - men i god stand
Emne: Biologi
Pearson Microbiology with Diseases by Taxonomy lærebog i biologi. Global Edition, femte udgave, af Robert W. Bauman. Bogen gennemgår mikrobiologi med fokus på sygdomme og taksonomi og er velegnet som grundbog til universitets- eller professionsstudier inden for biologi, medicin og beslægtede fag. Teksten er på engelsk og indeholder illustrationer, tabeller og eksempler til forståelse af mikroorganismer og deres betydning for sygdom.

Du skal være logget ind for at se brugerprofiler og sende beskeder.
Log indSidst redigeret: 7.2.2026 kl. 18:01 ・ Annonce-ID: 18449663